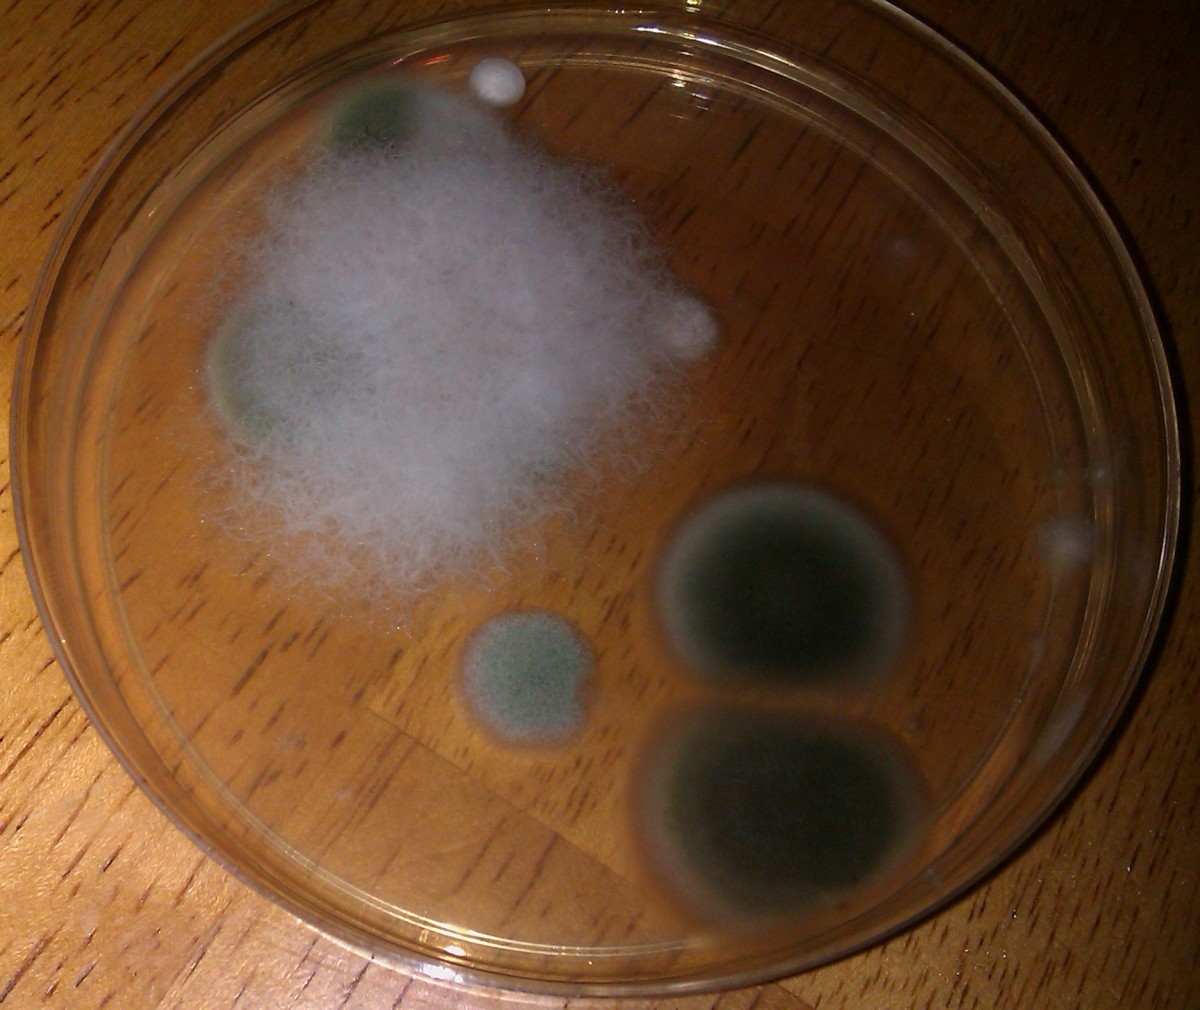

Petri Dish Mold Identification Chart
Petri Dish Mold Identification Chart - Web petri dishes are used to grow mold spores in the air, but they cannot identify the type, toxicity, or location of. Web free mold id guide: Web learn how to identify mold growing on petri dishes or culture plates using photos and microscopy. Web may 22, 2022 by jason. Web see photos of mold growing in petri dishes and learn how to identify different types of mold. Black mold is not a species or specific kind of mold, and neither is toxic. Find out why petri dish. Molds come in many colors including white. Web mold growing in petri dishes. Web learn how to observe and handle mold colonies on agar plates, and how to use a microscope and stain to identify molds to the genus level.
Mold Petri Dish Identification Chart vrogue.co
Web may 22, 2022 by jason. Web learn how to identify mold growing on petri dishes or culture plates using photos and microscopy. Web free mold id guide: Web petri dishes are used to grow mold spores in the air, but they cannot identify the type, toxicity, or location of. Molds come in many colors including white.
Mold Petri Dish Identification Chart vrogue.co
Find out why petri dish. Web may 22, 2022 by jason. Web learn how to observe and handle mold colonies on agar plates, and how to use a microscope and stain to identify molds to the genus level. Help identify the molds in your home with this image filled guide. Molds come in many colors including white.
Various Colorful Mold Types in a Petri Dish Stock Photo Image of
Web learn how to observe and handle mold colonies on agar plates, and how to use a microscope and stain to identify molds to the genus level. Web learn how to identify mold growing on petri dishes or culture plates using photos and microscopy. Web free mold id guide: Web may 22, 2022 by jason. Find out why petri dish.
List 98+ Pictures How To Grow Mold In A Petri Dish Excellent
Black mold is not a species or specific kind of mold, and neither is toxic. Web petri dishes are used to grow mold spores in the air, but they cannot identify the type, toxicity, or location of. Web see photos of mold growing in petri dishes and learn how to identify different types of mold. Web learn how to identify.
Mold Petri Dish Identification Chart vrogue.co
Help identify the molds in your home with this image filled guide. Web free mold id guide: Web see photos of mold growing in petri dishes and learn how to identify different types of mold. Black mold is not a species or specific kind of mold, and neither is toxic. Web mold growing in petri dishes.
Mold Petri Dish Identification Chart
Web petri dishes are used to grow mold spores in the air, but they cannot identify the type, toxicity, or location of. Web may 22, 2022 by jason. Web mold growing in petri dishes. Web see photos of mold growing in petri dishes and learn how to identify different types of mold. Web free mold id guide:
Mold Petri Dish Identification Chart
Find out why petri dish. Help identify the molds in your home with this image filled guide. Due to popular demand, we have now added a service to interpret mold results for. Web see photos of mold growing in petri dishes and learn how to identify different types of mold. Web may 22, 2022 by jason.
Mold Petri Dish Identification Chart
Web mold growing in petri dishes. Web may 22, 2022 by jason. Molds come in many colors including white. Web see photos of mold growing in petri dishes and learn how to identify different types of mold. Black mold is not a species or specific kind of mold, and neither is toxic.
Top 93+ Pictures Petri Dish Mold Identification Photos Superb
Help identify the molds in your home with this image filled guide. Web learn how to observe and handle mold colonies on agar plates, and how to use a microscope and stain to identify molds to the genus level. Web learn how to identify mold growing on petri dishes or culture plates using photos and microscopy. Web free mold id.
Mold Petri Dish Identification Chart
Molds come in many colors including white. Due to popular demand, we have now added a service to interpret mold results for. Web see photos of mold growing in petri dishes and learn how to identify different types of mold. Black mold is not a species or specific kind of mold, and neither is toxic. Help identify the molds in.
Help identify the molds in your home with this image filled guide. Due to popular demand, we have now added a service to interpret mold results for. Web may 22, 2022 by jason. Find out why petri dish. Web mold growing in petri dishes. Web learn how to identify mold growing on petri dishes or culture plates using photos and microscopy. Web free mold id guide: Molds come in many colors including white. Web petri dishes are used to grow mold spores in the air, but they cannot identify the type, toxicity, or location of. Black mold is not a species or specific kind of mold, and neither is toxic. Web see photos of mold growing in petri dishes and learn how to identify different types of mold. Web learn how to observe and handle mold colonies on agar plates, and how to use a microscope and stain to identify molds to the genus level.
Web Petri Dishes Are Used To Grow Mold Spores In The Air, But They Cannot Identify The Type, Toxicity, Or Location Of.
Web see photos of mold growing in petri dishes and learn how to identify different types of mold. Find out why petri dish. Web mold growing in petri dishes. Web may 22, 2022 by jason.
Due To Popular Demand, We Have Now Added A Service To Interpret Mold Results For.
Web learn how to identify mold growing on petri dishes or culture plates using photos and microscopy. Web free mold id guide: Web learn how to observe and handle mold colonies on agar plates, and how to use a microscope and stain to identify molds to the genus level. Help identify the molds in your home with this image filled guide.
Molds Come In Many Colors Including White.
Black mold is not a species or specific kind of mold, and neither is toxic.